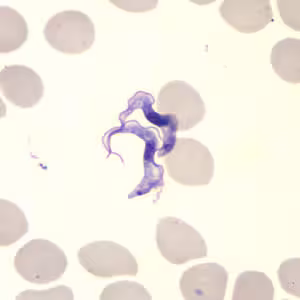
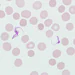
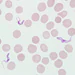
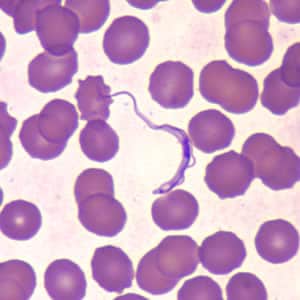
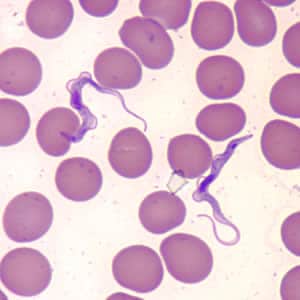

Trypanosomiasis, African
[Trypanosoma brucei gambiense] [Trypanosoma brucei rhodesiense]
Causal Agents
“African trypanosomes” or “Old World trypanosomes” are protozoan hemoflagellates of the genus Trypanosoma, in the subgenus Trypanozoon. Two subspecies that are morphologically indistinguishable cause distinct disease patterns in humans: T. b. gambiense, causing chronic African trypanosomiasis (“West African sleeping sickness”) and T. b. rhodesiense, causing acute African trypanosomiasis (“East African sleeping sickness”). The third subspecies T. b. brucei is a parasite primarily of cattle and occasionally other animals, and under normal conditions does not infect humans.
Life Cycle
 . Inside the host, they transform into bloodstream trypomastigotes
. Inside the host, they transform into bloodstream trypomastigotes  , are carried to other sites throughout the body, reach other body fluids (e.g., lymph, spinal fluid), and continue the replication by binary fission
, are carried to other sites throughout the body, reach other body fluids (e.g., lymph, spinal fluid), and continue the replication by binary fission  . The entire life cycle of African trypanosomes is represented by extracellular stages. The tsetse fly becomes infected with bloodstream trypomastigotes when taking a blood meal on an infected mammalian host
. The entire life cycle of African trypanosomes is represented by extracellular stages. The tsetse fly becomes infected with bloodstream trypomastigotes when taking a blood meal on an infected mammalian host  ,
,  . In the fly’s midgut, the parasites transform into procyclic trypomastigotes, multiply by binary fission
. In the fly’s midgut, the parasites transform into procyclic trypomastigotes, multiply by binary fission  , leave the midgut, and transform into epimastigotes
, leave the midgut, and transform into epimastigotes  . The epimastigotes reach the fly’s salivary glands and continue multiplication by binary fission
. The epimastigotes reach the fly’s salivary glands and continue multiplication by binary fission  . The cycle in the fly takes approximately 3 weeks. Rarely, T. b. gambiense may be acquired congenitally if the mother is infected during pregnancy.
. The cycle in the fly takes approximately 3 weeks. Rarely, T. b. gambiense may be acquired congenitally if the mother is infected during pregnancy.
Hosts and Vectors
Humans are considered the main reservoir for Trypanosoma brucei gambiense, but this species can also be found in animals, including primates and ungulates. Domestic cattle are thought to be the most epidemiologically-relevant animal reservoir of T. b. rhodesiense. The only known vector for each is the tsetse fly (Glossina spp.).
Geographic Distribution
T. b. gambiense is endemic in West and Central Africa. T. b. rhodesiense is restricted to East and Southeast Africa. These ranges do not overlap, although in Uganda both subspecies are co-endemic, with T. b. gambiense found near the northern border and T. b. rhodesiense is found in the central and southern regions of that country.
Clinical Presentation
Infection occurs in two stages which may sometimes be preceded by the development of a trypanosomal chancre on the site of inoculation within days of being bitten by an infected fly (most commonly occurs with T. b. rhodesiense). First-stage disease (haemolymphatic) involves nonspecific signs and symptoms such as intermittent fever, pruritus and lymphadenopathy. Posterior triangle cervical lymphadenopathy, or “Winterbottom’s sign” is commonly seen in T. b. gambiense infections, but lymphadenopathy can also be seen in the axillar, inguinal and epitrochlear regions. Enlarged lymph nodes tend to be submandibular, axillary and inguinal in T. b. rhodesiense.
In the second-stage disease (meningoencephalitic), invasion of the central nervous system causes a variety of neuropsychiatric manifestations including sleep disorders, hence the common name “African sleeping sickness”. Severe cardiac involvement with electrocardiogram abnormalities consistent with perimyocarditis are also observed. These alterations are generally mild in in T. b. gambiense infections but are more severe and appear earlier in T. b. rhodesiense infections. The course of infection is much more acute and rapid with T. b. rhodesiense than T. b. gambiense, and both infections are almost invariably fatal without treatment.

Laboratory Diagnosis
The diagnosis rests upon demonstrating trypanosomes by microscopic examination of chancre fluid, lymph node aspirates, blood, bone marrow, or, in the late stages of infection, cerebrospinal fluid. A wet preparation should be examined for the motile trypanosomes, and in addition a blood smear (thin or thick) should be fixed, stained with Giemsa (or Field), and examined. Concentration techniques can be used prior to microscopic examination. For blood samples, these include centrifugation followed by examination of the buffy coat; mini anion-exchange/centrifugation; and the Quantitative Buffy Coat (QBC) technique. For other samples such as spinal fluid, concentration techniques include centrifugation followed by examination of the sediment. Isolation of the parasite by inoculation of rats or mice is a sensitive method, but its use is limited to T. b. rhodesiense.
Antibody Detection
Rapid tests for T. b. gambiense are used for the screening of whole blood for control/elimination ; performance is variable depending on endemicity. Several of these kits are commercially available and include dipstick and card agglutination formats. However, with T. b. rhodesiense, seroconversion occurs after the onset of clinical symptoms and thus antibody detection is of limited use.
Molecular Detection
No nucleic acid-based tests are validated for the diagnosis of African trypanosomiasis, and diagnostic performance varies considerably among these tests.
Laboratory Safety
Standard safety protocols for handling blood and sharps (https://www.cdc.gov/dpdx/diagnosticprocedures/blood/safety.html). As with all bloodborne pathogens, precautions need to be taken to reduce risk of needle sticks or other exposures. At least one report of laboratory-acquired African trypanosomiasis exists, in a technician that experienced a needle stick while inoculating animals .
The CDC currently does not offer any serologic or molecular tests for African trypanosomiasis.
Suggested Reading
Büscher, P., Cecchi, G., Jamonneau, V., Priotto, G. 2017. Human African trypanosomiasis. The Lancet 390 (10110), pp. 2397-2409
DPDx is an educational resource designed for health professionals and laboratory scientists. For an overview including prevention, control, and treatment visit www.cdc.gov/parasites/.

